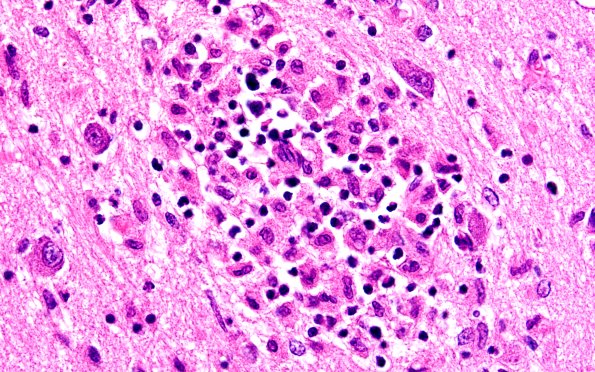
4B7 Lymphohistiocytosis (Case 4) H&E N3 60X

Table of Contents
Washington University Experience | MISCELLANEOUS | Familial erythrophagic lymphohistiocytosis | 4B7 Lymphohistiocytosis (Case 4) H&E N3 60X
Higher magnification of the infiltrate demonstrates a number of inflammatory cell types including lymphocytes and impressive numbers of histiocytes. (H&E)